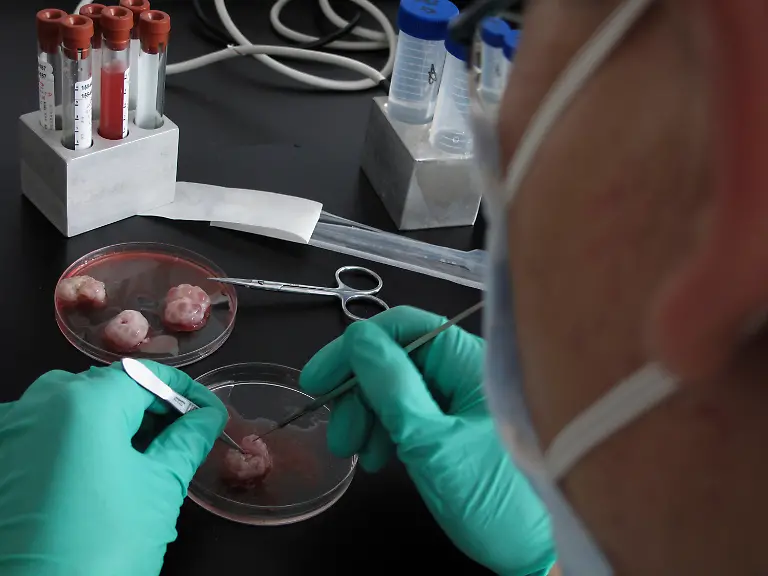
researcher

Bilderserien

Sensationell, nicht einzigartigDolly, Snuppy und andere Klone
23.11.2010, 13:30 Uhr
Wegweisend in der Heilung von Krankheiten oder ein unmoralischer Eingriff in den Lauf der Natur? Klonen ist so umstritten wie kaum ein anderes Thema. 1996 machte Dolly von sich reden. Längst haben sich die Klone von einst auf natürlichem Wege fortgepflanzt.